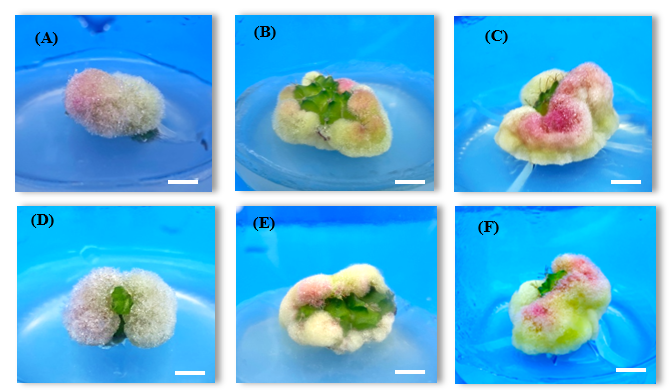
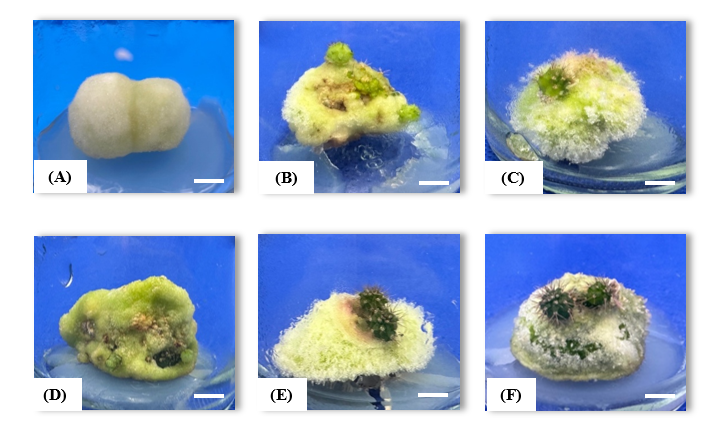

Trends
Sci.
2025; 22(7): 9827
In Vitro Propagation of Gymnocalycium mihanovichii LB2178 Agua Dulce (Cactaceae) and Genetic Stability Assessment Using Simple Sequence Repeat (SSR) Markers
Phakarat Rotduang1, Supawadee Thawaro2,* and Tassanee Khawniam3
1Department of Creative Innovation in Science and Technology, Faculty of Science and Technology,
Nakhon Si Thammarat Rajabhat University, Nakhon Si Thammarat 80280, Thailand
2Department of Biology, Faculty of Science and Technology, Nakhon Si Thammarat Rajabhat University,
Nakhon Si Thammarat 80280, Thailand
3Department of Agricultural Innovation and Management Division, Faculty of Natural Resources,
Prince of Songkla University, Songkhla 90110, Thailand
(*Corresponding author’s e-mail: [email protected])
Received: 21 January 2025, Revised: 5 April 2025, Accepted: 12 April 2025, Published: 10 June 2025
Abstract
The Gymnocalycium mihanovichii LB2178 Agua Dulce is a popular variety of cactus, known for its slightly raised skin known as “stripes” or bone pattern. It is also in high commercial demand. Therefore, the objective of this study were to study the effect of plant growth regulators and various explants fragmentation on callus induction and plant regeneration of G. mihanovichii LB2178 Agua Dulce and assessment genetic stability by SSR markers. The 1 cm seedlings of G. mihanovichii LB2178 Agua Dulce explant and callus were used as plant material. After 3 months of culture, the results showed that the explant sectioned longitudinally were cultured on MS medium supplemented with 2 mg/L 2,4-D, which gave the highest survival rate, 100 %, the highest callus induction, 100 % and the highest callus fresh weight, 2.72 g. The explant sectioned transversally were cultured on MS medium supplemented with 1 mg/L 2,4-D gave the highest anthocyanin contents, 0.00149 mg/gFW. The anatomical features of the callus derived from the tissue properties of the callus generated from transversely sectioned plant tissue culture, the epidermis layer is clearly visible, and there are vascular bundles arranged around the stem. The callus fragments were cultured on MS medium supplemented with 0.5 mg/L NAA and 3.5 mg/L BA gave the highest survival rate, 100 %, shoot induction, 90 %, a number of shoots, 2.20 shoots/explant and the shoot length, 0.28 cm. Assessment of genetic fidelity was performed on the G. mihanovichii LB2178 Agua Dulce micro propagated plantlets using SSR analysis with 8 SSR primers. The range of the chosen primers was 100 - 1,500 bp. The 4 of the 8 examined primers exhibited no polymorphism, whereas primer 4 displayed 83.33 % polymorphism.
Keywords: Gymnocalycium mihanovichii LB2178 agua dulce, In vitro, Genetic stability, SSR markers, 2,4 Dichlorophenoxyacetic acid, Anthocyanin, Histological
Introduction
Cactus or cactus family (Cactaceae) is one of the plant groups with high morphological diversity. There are 127 genera and approximately 1,430 - 2,000 species reported worldwide [1-3]. Most of them are densely distributed in South America, especially in Mexico, and in North America, including the United States and
Canada [4]. About 641 species of cactus [5] are cultivated as ornamental plants with high market value [6]. In addition, some cactus genera are used as food plants and eaten as fruits. And used as plants in the livestock feed industry [7].
Cactus has special characteristics. It has its own unique characteristics, namely the morphology of the succulent stem, round, cylindrical or serrated stem, which grows as a single stem or a clumping stem, especially the leaves that have evolved into thorns to reduce plant transpiration. In addition, cacti are plants with beautiful flowers of various shapes, such as funnel-shaped, bell-shaped, dish-like and tubular, as well as stems and flowers of various colors, such as yellow, purple, pink, red, white, cream, etc. [8]. Due to their unique qualities, cacti have gained popularity as ornamental plants that can be grown in homes and offices. As a result, 130 different species of cacti are imported and exported from 182 countries [9,10], especially Gymnocalycium mihanovichii [11] or Gymnocalycium mihanovichii is one of the Gymnocalycium genus, the cactus family, which is very popular (average 55 %) among cactus lovers (Cactus lovers) compared to other types of cactus (45 %). It has a total value of up to 2 million baht. This is because the plant has unique characteristics of the stem, stem color, thorn characteristics, shape and color of the flowers which are very diverse. It has a round stem. The number of lobes of LB2178 is usually from 9 up to 13 lobes. The lobes are thin. Another highlight is the skin texture. It will be seen as a green pattern alternating with dark green or black. It will be slightly raised. This pattern is called “stripes” or bone pattern. Because it is easy to grow and beautiful, G. mihanovichii LB2178 Agua Dulce is a popular cactus. It is considered one of the easiest cactus species to grow in Thailand and is a type that is popular all over the world. Some species are popular and have higher prices than normal [12].
This cactus has been cultivated and improved for a long time until it has hybrids that are different from the original, such as variegated Gymnocalycium or some plants have longer and larger thorns than before, resistant to hot weather. In addition, the cactus species G. mihanovichii LB2178 Agua Dulce is still in demand in the market because it is an ornamental plant with beautiful colors [13]. Currently, plant tissue culture techniques have been introduced to help increase the number of plants in a short period of time, including being applied in plant breeding to expand commercial plants [14].
The propagation of cacti by tissue culture technique has a faster propagation rate than natural propagation, which is very important, especially for cacti, which are slow-growing plants [15]. The propagation of cacti by tissue culture technique has many advantages, such as the control of humidity, sugar concentration and amount of plant growth regulators (PGRs), etc., resulting in a growth that is several times faster than natural [16]. In addition, the tissue culture technique allows propagation throughout the year, regardless of the season [17].
From the study of callus induction in cacti, 2,4-D is commonly used, such as Gymnocalycium mihanovichii [18,19], Parodia magnifica syn. Notocactus magnificus [20] and Opuntia ficus-indica. The 2,4-D is an important substance for plant growth in the auxin group, affecting cell division and cell size expansion when auxin is used together with cytokinin in callus [21]. Cultivation of various types of cactus parts and the use of growth regulators, which are plant hormones in the auxin and cytokinin groups are effective in accelerating the growth of plant parts. When examining the genetic variability, it was found that there was a high rate of shoot multiplication, but the resulting shoots had a morphology similar to the mother plant and had a low risk of genetic traits different from the mother plant [22]. However, there is limited information on the cultivation of various types of cactus parts to study genetic variability.
As molecular markers, SSRs are more informative than the biallelic single nucleotide polymorphism (SNP) markers as the former tend to have many alleles per locus [23]. Further, being co-dominant means that SSRs are valuable over dominant molecular markers as they will be relatively variable and may easily differentiate between homozygous and heterozygous individuals [24,25]. Additionally, SSRs are able to identify cultivars that are morphologically similar [26] and even determine gene flow incidents among individuals of different populations or closely related species [27,28].
This research therefore chose to use the cactus parts of the species G. mihanovichii LB2178 Agua Dulce because it is a popular species and has high commercial demand. The objectives of this study were to propagate and develop new plants of the cactus G. mihanovichii LB2178 Agua Dulce. The cactus G. mihanovichii LB2178 Agua Dulce’s genetic variability was examined through the use of molecular markers and the cultivation formula.
Currently, there are no studies related to in vitro shoot production of G. mihanovichii LB2178 Agua Dulce. Therefore, basic studies are needed so that future studies can explore the ornamental and economic potential of the species. This protocal developed in this research study increase the number of plantlets that were mass in short time and no variation between mother plant and in vitro plantlets. Causing another cactus species to adapt for export. Therefore, in order to investigate the ornamental and economic possibilities of another cactus species, basic research is required.
Materials and methods
Effect of different explant fragmentation and different concentrations of 2,4 Dichlorophenoxyacetic acid (2,4-D) on callus induction of G. mihanovichii LB2178 Agua Dulce
1) The 1 cm seedlings of G. mihanovichii LB2178 Agua Dulce were cut off the shoot and divided into 2 types of parts: A cross-sectional piece with a height of 3 - 4 mm and a longitudinal cut.
2) The 0.5 cm shoot explants were cultured on MS medium supplemented with 0, 1 and 2 mg/L 2,4-D. All culture mediums were supplemented with 30 g/L of sucrose and 8 g/L of agar. The pH was adjusted to 5.7. The culture was kept in 3,000 lux light intensity for 14 h per day at 25 ± 2 °C and subcultured every 4 weeks on the same medium component for 3 months. The survival rate, percentage of callus induction and callus fresh weight were recorded after 3 months of culture. The experiment design was a completely randomized design (CRD), and the mean differences were compared using Duncan’s multiple range test (DMRT).
Quantification of anthocyanin
The induced callus explant, 0.5 g of fresh weight were extracted for anthocyanin content according to the method of Ereifej et al. [29]. Each vial included 3 randomly selected callus samples, which were then submerged in 0.1 M hydrochloric acid, 5 mL of methanol and incubated at 4 °C for 24 h. After that, they were centrifuged at 1,000 rpm for 10 min. The supernatant was then measured for absorbance at 530 and 657 nm to calculate anthocyanin content according to the method of Rabino and Mancinelli [30]. Calculation of anthocyanin using the formula:
AC = (absorbance×449.2×DF)/(29,000×sample weight (g))
where AC is anthocyanin contents (mg/gFW).
absorbance (A) = (A530 − 0.25 A657)
Dilution factor (DF) = final volume/initial volume (mL)
Histological study of G. mihanovichii LB2178 agua dulce
Histological study of G. mihanovichii LB2178 Agua Dulce by collecting callus samples derived from shoot cultured of cactus after cultured for 3 months by collecting 3 replicates each. The plant tissues were cut longitudinally and transversely with a razor blade. Using a paintbrush, select pieces of plant tissue and place them on a slide. Add a little water to prevent drying. Examine them under a microscope with the lowest objective lens. Then, stain with safranin O for about 20 - 30 s and wash off the color by dropping water on the plant tissue and blotting it with tissue paper or using a paintbrush to wash it in distilled water in a petri dish. Add a little water. Cover with a coverslip. Use a tissue to blot up the water and stain and wipe the bottom of the slide dry. The prepared slides were examined under a microscope, starting with the lowest objective lens and going up to 40×. Compare the differences in the callus structures of G. mihanovichii LB2178 Agua Dulce.
Effect of NAA and BA concentrations on shoot induction of G. mihanovichii LB2178 agua dulce
The 0.5 cm callus explants obtained from experiment 1.1 were cultured on MS medium supplemented with 0 and 0.5 mg/L NAA and 0, 2.5 and 3.5 mg/L BA. The culture was kept in 3,000 lux light intensity for 14 h per day at 25 ± 2 °C and subcultured every 4 weeks on the same medium component for 3 months. The survival rate, percentage of shoot induction, number of shoots per explant and shoot length were recorded after 3 months of culture. The experiment design was a completely randomized design (CRD), and the mean differences were compared using Duncan’s multiple range test (DMRT).
Genetic variability of the G. mihanovichii LB2178 agua dulce using SSR markers
Plant DNA extraction
Callus samples of G. mihanovichii LB2178 Agua Dulce cultured on medium containing various concentrations of growth regulators, fresh weight 0.2 g each 3 samples. The callus samples were ground in a mortar and pestle, added 750 µL of CTAB (Cetyl Trimethyl Ammonium Bromide) (before use, incubated at 60 °C), ground until homogeneous, poured into a microcentrifuge tube, incubated in a water bath at 60 °C for 1 h (invert the tube every 15 min), added 750 µL of chloroform, inverted the tube 200 - 300 times, centrifuged at 12,000 rpm for 10 min, aspirated the supernatant into a new tube, added 750 µL of isopropanol (isopropanol on ice), inverted the tube until DNA precipitate was seen, spin to precipitate DNA, pour isopropanol, discard and wash the DNA precipitate with 70 % ethyl alcohol twice (refrigerate the 70 % ethyl alcohol before using). Pour out the 70 % ethyl alcohol and let it dry for 2 h. Add 20 - 30 µL of TE buffer and measure the DNA content using a NanoDrop Microvolume Spectrophotometer.
Polymerase Chain Reaction (PCR) amplification
The PCR technique was used to amplify DNA using 8 pairs of forward and reverse primers: L10464 F, L10464 R, L5354 F, L5354 R, L28477 F, L 28477 R, L 161092 F, and L 161092 R. The DNA was amplified by PCR reaction from a total volume of 13 μL, consisting of 6.25 μL of 2× PCR, 0.5 μL of F-primer, 0.5 μL of R-primer, 1 μL of sample DNA, and 4.75 μL of sterile distilled water. The total volume was 13 μL. The reaction temperature was set as follows: Pre-denaturation. The initial temperature was 95 °C for 1 min, the denaturation temperature was 95 °C for 30 min, the annealing temperature was 72 °C for 1 min, the extension temperature was 72 °C for 1 min, and the steps 2 - 4 were repeated for 35 cycles. The final extension temperature was 72 °C for 10 min. The DNA bands were then separated using an automatic DNA sizing machine.
Gel electrophoresis and genetic analysis
The synthesized DNA products were examined by electrophoresis in 1 % agarose gel in 1× TBE buffer using 100 V potential for 45 min. The gel was then stained with fluorescence dye for 15 min and washed with distilled water for 5 min. The gel was examined under ultraviolet light using an image recorder and compared with a 1 kb DNA ladder and a 100 bp DNA ladder plus standard DNA. The appropriate primers and temperatures were selected that could increase the amount and give clearly distinguishable DNA bands.
Statistical analysis
A completely randomized design with 3 replicates was performed for experimental design and statistical analysis. Data was analyzed using ANOVA.
Results and discussion
Effect of explant fragmentation and different concentrations of 2,4 Dichlorophenoxyacetic acid (2,4-D) on callus induction of G. mihanovichii LB2178 agua dulce
The explant cross-sectional piece with a height of 3 - 4 mm and a longitudinal cut were culture on MS medium supplemented with 0, 1 and 2 mg/L 2,4-D. The result found that the explant sectioned longitudinally were cultured on MS medium supplemented with 0 mg/L 2,4-D, the explant sectioned transversally and longitudinally were cultured on MS medium supplemented with 1 mg/L 2,4-D and the explant sectioned longitudinally were cultured on MS medium supplemented with 2 mg/L 2,4-D gave the highest survival, 100 %, followed by the explant sectioned transversally were cultured on MS medium supplemented with 2 mg/L 2,4-D and the explant sectioned transversally were cultured on MS medium supplemented with 0 mg/L 2,4-D, 93.33 and 86.67 % respectively, not significant difference at p ≤ 0.05. For the callus induction, the result found that the explant sectioned transversally and longitudinally were cultured on MS medium supplemented with 2 mg/L 2,4-D gave the highest percentage of callus induction, 100 %. The explant sectioned longitudinally and transversally were cultured on MS medium supplemented with 1 mg/L 2,4-D, 96.67 and 93.33 %, respectively, followed by the explant sectioned transversally and longitudinally were cultured on MS medium supplemented with 0 mg/L 2,4-D gave the same percentage of callus induction, 33.33 %. significant difference at p ≤ 0.05.
For callus fresh weight, the result found that the explant sectioned longitudinally were cultured on MS medium supplemented with 2 mg/L 2,4-D gave the highest of callus fresh weight, 2.72 g. followed by the explant sectioned transversally and longitudinally were cultured on MS medium supplemented with 1 mg/L 2,4-D, the explant sectioned transversally were cultured on MS medium supplemented with 2 mg/L 2,4-D, the explant sectioned longitudinally were cultured on MS medium supplemented with 0 mg/L 2,4-D and the explant sectioned transversally were cultured on MS medium supplemented with 0 mg/L 2,4-D, 2.39, 2.34, 1.85, 0.27 and 0.24 g, respectively, significant difference at p ≤ 0.05 (Table 1 and Figure 1).
The result found that the explants sectioned longitudinally were cultured on MS medium supplemented with 2 mg/L 2,4-D gave the highest percentage of survival. Because the longitudinally sectioned explant will have a high surface area in contact with the culture medium when placed on it, allowing for a considerable quantity of medium absorption, callus induction and callus fresh weight to be possible. In addition, the addition of 2,4-D hormone, a crucial component for plant growth in the auxin group, to the culture medium causes cell division and expansion. Callus induction from shoot cultured with 2,4-D is a propagation technique that stimulates the division of somatic cells to form a loose group of parenchyma cells. Callus can be induced and developed into new plants and roots later, which is a process of propagating cacti to produce a large number of new plants. The callus induction step is an important step because callus can increase in volume quickly and is a starting cell for inducing new plants. According to reports, the results indicated that callus formation was induced in all treatments 6 days after culturing. There were significant differences in growth parameters, including fresh weight, volume, moisture, tissue firmness, total phenols, total flavonoids and antioxidant activity of the callus (p < 0.01) and dry weight of callus (p < 0.05). Explants containing a segment of central tissue, yielded the least favorable results in most of experimental treatments, and the application of 2,4-D in the absence of BA had an inhibitory and toxic effect on the San Pedro cactus explants. Habibeh et al. [31]; Martıinez et al. [32] reported that callus formation from embryos culture of O. streptacantha, O. Megacantha, and O. ficus-indica was observed in all media supplemented with 2,4-D but not in media containing only BA. The combination of 3 mg/L 2,4-D and 0.5 mg/L BA produced the best response, with 70 % of callus induction in O. streptacantha and 100 % in O. megacantha and O. ficus-indica explants at day 15 of culture. similar to those reports from Ho et al. [33]. Different characteristics of callus were found in different concentrations of 2,4-D. CIM containing 2.0 mg/L 2,4-D gave the best response in callus formation (64.38 %) and desired morphology of embryogenic callus as yellowish white color with globular structure similar to those reports from Libin et al. [34]. In addition, petal, single flower and mix flowers of rubber tree derived calli were achieved on MS medium supplemented with 2.0 mg/L BA and 1.5 mg/L 2,4-D. The callus grew rapidly on this medium. After culturing the callus on this medium for 12 weeks with subculture at 4 weeks intervals, EC were formed from all 3 types of floral explants except lTCL which failed to form EC. Floral EC provided SEs which developed from peripheral cells of the callus [35].
Table 1 Effect of explant fragmentation and different concentrations of 2,4-Dichlorophenoxyacetic acid (2,4-D) on callus induction of G. mihanovichii LB2178 agua dulce.
Culture medium |
Explant fragmentation |
Survival (%) |
Callus Induction (%) |
Callus fresh weight (g) |
MS |
Sectioned transversally |
86.67 |
33.33b |
0.24c |
Sectioned longitudinally |
100.00 |
33.33b |
0.27c |
|
MS + 1 mg/L 2,4-D |
Sectioned transversally |
100.00 |
93.33a |
2.39ab |
Sectioned longitudinally |
100.00 |
96.67a |
2.34ab |
|
MS + 2 mg/L 2,4-D |
Sectioned transversally |
93.33 |
100.00a |
1.85b |
Sectioned longitudinally |
100.00 |
100.00a |
2.72a |
|
F-test |
Ns |
* |
* |
|
C.V. (%) |
18.00 |
38.00 |
56.00 |
|
* = significantly difference at p ≤ 0.05.
![]()
![]()
![]()
![]()
![]()
![]()
F![]()
![]()
![]()
![]()
![]()
![]() igure
1
Characteristics
of callus formation derived from explant fragmentation of G.
mihanovichii
LB2178 Agua Dulce were cultured on MS medium supplemented with
various concentrations of 2,4-D after culturing for 2 months
(A) MS: Sectioned transversally, (B) MS: Sectioned longitudinally,
(C) MS + 1 mg/L 2,4-D: Sectioned transversally, (D) MS + 1 mg/L
2,4-D: Sectioned longitudinally, (E) MS + 2 mg/L 2,4-D: Sectioned
transversally, (F) MS + 2 mg/L 2,4-D: Sectioned longitudinally (bar
= 1 cm).
igure
1
Characteristics
of callus formation derived from explant fragmentation of G.
mihanovichii
LB2178 Agua Dulce were cultured on MS medium supplemented with
various concentrations of 2,4-D after culturing for 2 months
(A) MS: Sectioned transversally, (B) MS: Sectioned longitudinally,
(C) MS + 1 mg/L 2,4-D: Sectioned transversally, (D) MS + 1 mg/L
2,4-D: Sectioned longitudinally, (E) MS + 2 mg/L 2,4-D: Sectioned
transversally, (F) MS + 2 mg/L 2,4-D: Sectioned longitudinally (bar
= 1 cm).
Quantification of anthocyanin
The induced callus fragments, weighing 0.5 g were extracted for anthocyanin content according to the method of Ereifej et al. Three callus samples were randomly sampled in each bottle and the callus were immersed in 0.1 M hydrochloric acid, 5 mL of methanol and incubated at 4 °C for 24 h. After that, they were centrifuged at 1,000 rpm for 10 min. The supernatant was then measured for absorbance at 530 and 657 nm to calculate anthocyanin content according to the method of Rabino and Mancinelli. The result found that the explant sectioned transversally were cultured on MS medium supplemented with 1 mg/L 2,4-D gave the highest anthocyanin contents, 0.00149 mg/gFW, followed by the explant sectioned transversally were cultured on MS medium supplemented with 2 mg/L 2,4-D and the explant sectioned longitudinally were cultured on MS medium supplemented with 2 mg/L 2,4-D, 0.00110 and 0.00109 mg/gFW, respectively. The explant sectioned transversally and longitudinally were cultured on MS medium supplemented with 0 mg/L 2,4-D gave Anthocyanin contents 0.00108 mg/gFW, the explant sectioned longitudinally were cultured on MS medium supplemented with 1 mg/L 2,4-D, 0.00076 mg/gFW, respectively, significant difference at p ≤ 0.05. (Table 2 and Figure 1).
The result found that the explant sectioned transversally were cultured on MS medium supplemented with 1 mg/L 2,4-D gave the highest anthocyanin contents because anthocyanin production is related to plant development and cellular metabolic processes. Both processes are influenced by both extrinsic and extrinsic factors such as the type and source of plant parts, culture medium, plant growth regulators, cell culture conditions, and pH of the medium. In addition, the source of nitrogen or carbon, as well as the type and concentration of sugar, also affect anthocyanin production in vitro. It is important to study the comparative anthocyanin production between plant cells in vitro and ex vitro to confirm whether the anthocyanins produced are similar in quantity or properties [36]. According to reports, there seems to be a positive relationship between callus formation and anthocyanin content. It was observed that treatments which promoted higher callus formation produced higher anthocyanin. It is worth mentioning that among the interactions between 2,4-D and BA, the concentration of 2.5 ppm of both plant growth regulators produced the highest percentage of callus formation. The same treatment combinations produced the highest anthocyanin at 448.66 mg/g. The anthocyanin content decreased along with the callus formation [37].
Table 2 Effect of explant fragmentation and different concentrations of 2,4-Dichlorophenoxyacetic acid (2,4-D) on anthocyanin production of G. mihanovichii LB2178 Agua Dulce.
Culture medium |
Explant fragmentation |
Anthocyanin contents (mg/gFW) ± S.D. |
MS |
Sectioned transversally |
0.00108 ± 0.00022ab |
Sectioned longitudinally |
0.00108 ± 0.00015ab |
|
MS+1 mg/L 2,4-D |
Sectioned transversally |
0.00149 ± 0.00059a |
Sectioned longitudinally |
0.00076 ± 0.00004b |
|
MS+2 mg/L 2,4-D |
Sectioned transversally |
0.00110 ± 0.00024ab |
Sectioned longitudinally |
0.00109 ± 0.00004ab |
|
F-test |
* |
|
C.V. (%) |
25.00 |
|
* = Significantly difference at p ≤ 0.05.
Histological study of G. mihanovichii LB2178 agua dulce
Histological study of G. mihanovichii LB2178 Agua Dulce by collecting callus samples derived from the shoot cultured of cactus after cultured for 3 months. The tissues were cut longitudinally and transversely with a razor blade. Compare the differences in the callus structures of G. mihanovichii LB2178 Agua Dulce. The result found that the callus’s anatomical features were derived from the tissue properties of the callus created from sectioned transversally plant tissue culture, with vascular bundles grouped around the stem and the epidermal layer plainly visible (Figures 2(A) and 2(C)). Spines are clearly evident around the callus that was created by sectioning plant tissue culture both longitudinally and transversally (Figures 2(A) and 2(B)). The characteristics of callus obtained from sectioned transversally and longitudinally cultures on MS-free medium and sectioned transversally plant tissue cultured on MS medium supplemented with 1 mg/L 2,4-D are compact callus, and the callus obtained from sectioned transversally and longitudinally cultures on MS-free medium, Sectioned longitudinally were cultured on MS medium supplemented with 1 mg/L 2,4-D, and sectioned transversally and longitudinally were cultured on MS medium supplemented with 2 mg/L 2,4-D are loosely adherent callus (friable callus). Callus formed from both sectioned transversally and longitudinally of plant tissue showed cells containing green pigment (Figures 2(A) - 2(E)) and purple pigment, which is anthocyanin (Figure 2(F)).
The results found that sectioned longitudinally plant tissue cultured on MS medium supplemented with 1 mg/L 2,4-D and sectioned transversally and longitudinally were cultured on MS medium supplemented with 2 mg/L 2,4-D. Loosely adherent callus (friable callus) was formed because [38]. 2,4-D is known as a strong synthetic auxin and popular as a growth regulator in plant tissue culture [39]. 2,4-D alone was often used for callus induction. According to reports, the explants of M. herrerae developed yellowish-green watery callus or green friable callus on nutrient medium MS containing TDZ (10.0 mM) and 2,4-D (5.0 mM) or TDZ (10.0 mM) and NAA (5.0 mM), respectively.

![]()
![]()
![]()
![]()
![]()
![]()
Figure 2 Histological study of G. mihanovichii LB2178 Agua Dulce by collecting callus samples derived from of shoot-cultured of cactus after cultured for 3 months. (A) MS: Sectioned transversally, (B) MS: Sectioned longitudinally, (C) MS + 1 mg/L 2,4-D: Sectioned transversally, (D) MS + 1 mg/L 2,4-D: Sectioned longitudinally, (E) MS + 2 mg/L 2,4-D: Sectioned transversally, (F) MS + 2 mg/L 2,4-D: Sectioned longitudinally (bar = 1 cm).
Effect of NAA and BA concentrations on shoot induction of G. mihanovichii LB2178 agua dulce
The 0.5 cm callus fragments from experiment 1.1 were cultured on MS medium supplemented with 0 and 0.5 mg/L NAA and 0, 2.5 and 3.5 mg/L BA. The culture was kept in 3,000 lux light intensity for 14 h per day at 25 ± 2 °C and subcultured every 4 weeks on the same medium component for 3 months. The result found that callus explants cultured on MS medium supplemented with 0.5 mg/L NAA and 3.5 mg/L BA gave the highest survival, 100 %, followed by MS medium supplemented with 0.5 mg/L NAA and 2.5 mg/L BA, MS medium supplemented with 0 mg/L NAA and 3.5 mg/L BA, MS medium supplemented with 0 mg/L NAA and 2.5 mg/L BA, MS medium supplemented with 0.5 mg/L NAA and 0 mg/L BA and MS medium supplemented with 0 mg/L NAA and 0 mg/L BA, 80.00, 73.33, 66.67, 60.00 and 53.33 %, respectively, with a significant difference at p ≤ 0.05. For the shoot induction, the result found that callus explants cultured on MS medium supplemented with 0.5 mg/L NAA and 3.5 mg/L BA gave the highest shoot induction, 90 %, followed by MS medium supplemented with 0.5 mg/L NAA and 2.5 mg/L BA, MS medium supplemented with 0 mg/L NAA and 3.5 mg/L BA, MS medium supplemented with 0 mg/L NAA and 2.5 mg/L BA, MS medium supplemented with 0.5 mg/L NAA and 0 mg/L BA and MS medium supplemented with 0 mg/L NAA and 0 mg/L BA, 80.00, 70.00, 53.33, 46.47 and 0.00 %, respectively. significant difference at p ≤ 0.05. For the number of shoots, the result found that callus explant were cultured on MS medium supplemented with 0.5 mg/L NAA and 3.5 mg/L BA gave the highest number of shoots per explant, 2.20 shoots/explant, followed by MS medium supplemented with 0.5 mg/L NAA and 2.5 mg/L BA, MS medium supplemented with 0 mg/L NAA and 3.5 mg/L BA, MS medium supplemented with 0 mg/L NAA and 2.5 mg/L BA, MS medium supplemented with 0.5 mg/L NAA and 0 mg/L BA and MS medium supplemented with 0 mg/L NAA and 0 mg/L BA, 1.80 shoots/explant, 1.47 shoots/explant, 1.00 shoots/explant, 0.80 shoots/explant and 0.00 shoots/explant, respectively, with a significant difference at p ≤ 0.05. For the shoot length, the result found that callus explant were cultured on MS medium supplemented with 0.5 mg/L NAA and 3.5 mg/L BA gave the shoot length, 0.28 cm, followed by MS medium supplemented with 0.5 mg/L NAA and 2.5 mg/L BA, MS medium supplemented with 0 mg/L NAA and 3.5 mg/L BA, MS medium supplemented with 0 mg/L NAA and 2.5 mg/L BA, MS medium supplemented with 0.5 mg/L NAA and 0 mg/L BA and MS medium supplemented with 0 mg/L NAA and 0 mg/L BA, 0.22 cm, 0.17 cm, 0.13 cm, 0.11 cm and 0.00 cm respectively, with a significant difference at p ≤0.05. (Table 3 and Figure 3) The result found that callus explants cultured on MS medium supplemented with 0.5 mg/L NAA and 3.5 mg/L BA gave the highest survival, the highest shoot induction, the highest number of shoots per explant and the highest shoot length because BA is a cytokinin growth stimulant that can stimulate cell division and new shoot growth, help create chlorophyll and strengthen the plant cell wall, which is necessary for cell division to create shoots, and NAA is an auxin growth regulator that stimulates cell elongation and root formation. The concentrations of both growth regulators are related, affecting the expression and growth of different plant parts [40]. According to reports, the higher number of shoot value obtained for M. glaucescens in the treatment of NAA (1.34 μM) combined with BAP (17.76 μM) may be related to the production of multiple shoots supplementary material). The % E value obtained in this treatment (45.8 %) was only half of what was seen in the control (95.8 %), the latter with an average NS of 1.3 and a maximum of 3 shoots/explant. In Launaea sarmentosa (Willd.) Kuntze, 2 types of explants, including leaf and stolon were applied to induce the multiple shoots by culturing on Murashige and Skoog (MS) medium supplemented with BA (0, 1 and 2 mg/L) and 2,4-D (0, 1, 2 and 4 mg/L). The optimal shoot induction medium for both explants was MS medium containing 2 mg/L BA (presented 100 % shoot induction) [41].
![]()
![]()
![]()
![]()
![]()
![]()
F![]()
![]()
![]()
![]()
![]() igure
3 Characteristics
of shoot induction of G.
mihanovichii LB2178
Agua Dulce were cultured on MS medium supplemented with various
concentrations of NAA and
BA
after culturing for 3 months. (A) MS + 0 mg/L NAA + 0 mg/L BA, (B)
MS + 0 mg/L NAA +2.5 mg/L BA, (C) MS + 0 mg/L NAA +3.5 mg/L BA, (D)
MS + 0.5 mg/L NAA +0 mg/L BA, (E) MS + 0.5 mg/L NAA +2.5 mg/L BA,
(F) MS + 0.5 mg/L NAA +3.5 mg/L BA (bar = 1 cm).
igure
3 Characteristics
of shoot induction of G.
mihanovichii LB2178
Agua Dulce were cultured on MS medium supplemented with various
concentrations of NAA and
BA
after culturing for 3 months. (A) MS + 0 mg/L NAA + 0 mg/L BA, (B)
MS + 0 mg/L NAA +2.5 mg/L BA, (C) MS + 0 mg/L NAA +3.5 mg/L BA, (D)
MS + 0.5 mg/L NAA +0 mg/L BA, (E) MS + 0.5 mg/L NAA +2.5 mg/L BA,
(F) MS + 0.5 mg/L NAA +3.5 mg/L BA (bar = 1 cm).
Table 3 Effect of NAA and BA concentrations on shoot induction of G. mihanovichii LB2178 agua dulce.
Culture medium |
Survival (%) |
Shoot Induction (%) |
Number of shoots per explant (shoots/explant) |
Shoot Length (cm) |
MS + 0 mg/L NAA + 0 mg/L BA |
53.33b |
0.00c |
0.00e |
0.00d |
MS + 0 mg/L NAA + 2.5 mg/L BA |
66.67b |
53.33b |
1.00cd |
0.13c |
MS + 0 mg/L NAA + 3.5 mg/L BA |
73.33ab |
70.00ab |
1.47bc |
0.17bc |
MS + 0.5 mg/L NAA + 0 mg/L BA |
60.00b |
46.47b |
0.80d |
0.11c |
MS + 0.5 mg/L NAA + 2.5 mg/L BA |
80.00ab |
80.00a |
1.80ab |
0.22ab |
MS + 0.5 mg/L NAA + 3.5 mg/L BA |
100.00a |
90.00a |
2.20a |
0.28a |
F-test |
* |
* |
* |
* |
C.V. (%) |
56.00 |
59.00 |
60.00 |
65.00 |
* = significantly difference at p ≤ 0.05.
Genetic variability of the G. mihanovichii LB2178 agua dulce using SSR markers
Assessment of genetic fidelity was performed on the G. mihanovichii LB2178 Agua Dulce micro propagated plantlets using SSR analysis with 8 SSR primers (Table 4; Figure 4). The selected primers gave DNA banding ranged from 100 - 1,700 bp. The DNA banding were varied from 1 to 6 bands of primer 3, 5, 7, 8 and primer 4, respectively. With the exception of primers 3, 4, 5, 7 and 8, the SSR amplification pattern observed with all primers showed that all bands generated by micropropagated plants were monomorphic and comparable to those of the mother plant. Primers 3, 5, 7 and 8 amplified only one monomorphic band (100 bp). Primer 4 was amplified 1 monomorphic band and 5 polymorphic bands (100 - 1,500 bp) produced by in vitro propagated clone 8, 9 and 10. The 8th clone was sectioned longitudinally, it formed a DNA banding with a moleculasr size of 300 and 1,400 bp. It was cultured on MS medium supplemented with 0 mg/L 2,4-D. The 9th clone was sectioned transversally and grown on MS medium supplemented with 1 mg/L 2,4-D produced a DNA banding with a molecular size of 200, 300, 400 and 500 bp. The 10th clone was sectioned longitudinally and grown on MS medium supplemented with 1 mg/L 2,4-D produced a DNA banding with a molecular size of 200, 300, 400 and 500 bp. Of the 8 primers analyzed, 4 primers showed 83.33 % polymorphism, respectively (Table 4). According to reports, it was not possible to establish a relationship between morphological and genetic variation in in vitro-regenerated shoots of M. glaucescens. Several shoots with morphological alterations did not present genetic polymorphism, but shoots without morphological alterations presented genetic polymorphisms when compared with their respective mother plants. Shoots produced in PGR-free media showed normal morphology (Supplementary material). In addition, the 3 SSR primers were reported to use in verification of genetic variation among early induce clones of rubber tree collected from different areas in southern Thailand. All primers showed polymorphism among rubber clones tested. However, these primers provided monomorphic bands in this present study indicated that somaclones obtained by this technique are uniformity. Hence, these primers could be used to verify genetic uniformity of in vitro regenerated plantlets [42].
Table 4 Primer type, total of number DNA pattern, polymorphic fragment and percentage of polymorphic fragment obtained from SSR analysis.
Primer |
Total of number DNA pattern |
Number of monomorphic banding |
Number of polymorphic banding |
Monomorphic banding (%) |
Polymorphic banding (%) |
DNA ladder (bp) |
Primer 1 (L10464-F, L10464-R) callus |
- |
- |
- |
- |
- |
- |
Primer 2 (L5354-F, L10464-R) callus |
- |
- |
- |
- |
- |
- |
Primer 3 (L28477-F, L28477-R) callus |
1 |
1 |
0 |
100 |
0 |
100 bp |
Primer 4 (L161092-F, L161092R) callus |
6 |
1 |
5 |
17.71 |
83.33 |
100 - 1,500 bp |
Primer 5 (L23031-F, L23031-R) callus |
1 |
1 |
0 |
100 |
0 |
100 bp |
Primer 6 (L37320-F, L37320-R) callus |
- |
- |
- |
- |
- |
- |
Primer 7 (L38909-F, L38909-R) callus |
1 |
1 |
0 |
100 |
0 |
100 bp |
Primer 8 (L86067-F, L86067-R) callus |
1 |
1 |
0 |
100 |
0 |
100 bp |
Total |
10 |
5 |
5 |
52.21 |
10.42 |
|
 Figure
4
DNA
Amplification pattern obtained with SSR primers. Lane Lander- DNA
ladder; Lane-M2 DNA from mother plant; Lane 7/1-13/3 DNA from
micropropagated plants.
Figure
4
DNA
Amplification pattern obtained with SSR primers. Lane Lander- DNA
ladder; Lane-M2 DNA from mother plant; Lane 7/1-13/3 DNA from
micropropagated plants.
Conclusions
The results showed that G. mihanovichii LB2178 Agua Dulce can be propagated using in vitro techniques. After 3 months of culture, the results showed that the explant sectioned longitudinally were cultured on MS medium supplemented with 2 mg/L 2,4-D, which gave the highest survival rate at 100 %, the highest callus induction at 100 % and the highest callus fresh weight, 2.72 g. The explants sectioned transversally were cultured on MS medium supplemented with 1 mg/L 2,4-D gave the highest anthocyanin contents 0.00149 mg/gFW. The anatomical characteristics of callus from the tissue characteristics of the callus formed from sectioned transversally plant tissue culture, the epidermis layer is clearly visible, and there are vascular bundles arranged around the stem. The callus fragments were cultured on MS medium supplemented with 0.5 mg/L NAA and 3.5 mg/L BA gave the highest survival rate at 100 %, shoot induction at 90 %, a number of shoots, 2.20 shoots/explant and the shoot length, 0.28 cm. Assessment of genetic fidelity was performed on the G. mihanovichii LB2178 Agua Dulce micro propagated plantlets using SSR analysis with 8 SSR primers. The selected primers gave ranged from 100 - 1,500 bp. Of the 8 primers analyzed, primer 4 showed 83.33 % polymorphism, respectively.
Acknowledgements
This work was supported by Agricultural Diversity and Biotechnology Research Unit, and the Science Center in the Faculty of Science and Technology, Nakhon Si Thammarat Rajabhat University, Thailand.
References
[1] G Rowley and M Kimnach. The new cactus lexicon. Cactus and Succulent Journal 2006; 78(6), 318-319.
[2] M Arakaki, PA Christin, R Nyffeler, A Lendel, U Eggli, RM Ogburn, E Spriggsa, MJ Moored and EJ Edwards. Contemporaneous and recent radiations of the world’s major succulent plant lineages. Proceedings of the National Academy of Sciences 2011; 108(20), 8379-8384.
[3] TH Hernández, HM Hernández, JAD Nova, R Puente, LE Eguiarte and S Magallón. Phylogenetic relationships and evolution of growth form in Cactaceae (Caryophyllales, Eudicotyledoneae). American Journal of Botany 2011; 98(1), 44-61.
[4] EF Anderson. The cactus family. Timber Press, Oregon, 2001, p. 562-564.
[5] B Goettsch, C Hilton-Taylor, G Cruz-Piñón, JP Duffy, A Frances, HM Hernández, R Inger, C Pollock, J Schipper, M Superina, NP Taylor, M Tognelli, AM Abba, S Arias, HJ Arreola-Nava, MA Baker, RT Bárcenas, D Barrios, P Braun, CA Butterworth, …, KJ Gaston. High proportion of cactus species threatened with extinction. Nature Plants 2015; 1, 15142.
[6] S Boonyang. Business plan for building a new business sb cactus garden: Small and medium-sized enterprises. Bangkok University, Bangkok, Thailand, 2016.
[7] MO Brutsch and MB Scott. Extending the fruiting season of spineless prickly pear (Opuntia ficus-indica). Journal of the South African Society for Horticultural Science 1991; 1, 73-76.
[8] JHC Sánchez and DS Croutch. Notes on the floral biology of Praecereus euchlorus subsp. euchlorus (Cactaceae). Schumannia 2008; 5, 102-103.
[9] T Galili. Dendextend: An R package for visualizing, adjusting and comparing trees of hierarchical clustering. Bioinformatics 2015; 31(22), 3718-3720.
[10] A Novoa, J Rodr´ıguez, AL Nogueira, DM Richardson and L Gonzalez. Seed characteristics in Cactaceae: Useful f,diagnostic features for screening species for invasiveness. South African Journal of Botany 2016; 105, 61-65.
[11] NL Britton and JN Rose. The Cactaceae: Descriptions and illustrations of plants of the cactus family. The Carnegie Institution, Washington, 1922.
[12] P Supanantananon. Cactus. Amarin Printing and Publishing, Bangkok, Thailand, 2019, p. 7-10.
[13] S Kanchanakul. Roiphan phrueksa cactus. Amarin Printing and Publishing, Bangkok, Thailand, 2014, p. 105-108.
[14] S Ramasoot. Textbook on plant tissue culture. Nakhon Si Thammarat Rajabhat University, Nakhon Si Thammarat, Thailand, 2016, p. 106-108.
[15] MSS Díaz, RM Ontiveros, AA Gómez and MDLS Diaz. In vitro organogenesis of Pelecyphora aselliformis Erhenberg (Cactaceae). In vitro Cellular and Developmental Biology - Plant 2003; 39, 480-484.
[16] EPM Balch and CAD Figueroa. In vitro propagation of Pelecyphora aselliformis Ehrenberg and P. strobiliformis Werdermann (Cactaceae). In vitro Cellular and Development Biology - Plant 2002; 38, 73-78.
[17] JL Rumińska and D Kulus. Micropropagation of cacti: A review. Haseltonia 2014; 2014(19), 46-63.
[18] JL Rumińska and A Fijalkowska. The rate of callus growth and regeneration of embryogenic structures in cactus of Gymnocalycium genus depending on the light conditions. Zeszyty Problemowe Postepw Nauk Rolniczych 2006; 510, 325-331.
[19] JL Rumińska and D Kulus. Micropropagation of cacti: A review. Haseltonia 2014; 2014(19), 46-63.
[20] LA Medeiros, RCS Ribeiro, LA Gallo, ET Oliveira and MESP Dematte. In vitro propagation of Notocactus magnificus. Plant Cell, Tissue and Organ Culture 2006; 84, 165-169.
[21] JL Müller. Auxin conjugates: Their role for plant development and in the evolution of land plants. Journal of Experimental Botany 2011; 62(6), 1757-1773.
[22] GT Silva, SV Resende, AL Brito, HB Bezerra, JRF Santana and AS Schnadelbach. In vitro shoot production, morphological alterations and genetic instability of Melocactus glaucescens (Cactaceae), an endangered species endemic to eastern Brazil. South African Journal of Botany 2018; 115, 100-107.
[23] MT Hamblin, ML Warburton and ES Buckler. Empirical comparison of simple sequence repeats and single nucleotide polymorphisms in assessment of maize diversity and relatedness. PLoS One 2007; 2(12), e1367.
[24] D Csencsics, S Brodbeck and R Holderegger. Cost-effective, species-specific microsatellite development for the endangered dwarf bulrush (Typha minima) using next generation sequencing technology. Journal of Heredity 2010; 101(6), 789-793.
[25] S Dutta, G Kumawat, BP Singh, DK Gupta, S Singh, V Dogra, K Gaikwad, TR Sharma, RS Raje, TK Bandhopadhya, S Datta, MN Singh, F Bashasab, P Kulwal, KB Wanjari, RK Varshney, DR Cook and NK Singh. Development of genic-SSR markers by deep transcriptome sequencing in pigeonpea [Cajanus cajan (L.) Millspaugh]. BMC Plant Biology 2011; 11, 17.
[26] M Caruso, S Curr and CG Las. Microsatellite markers help to assess genetic diversity among Opuntia Ficusindica cultivated genotypes and their relation with related species. Plant Systematics and Evolution 2010; 290, 85-97.
[27] WS Fava, VGN Gomes, AP Lorenz and GM Paggi. Cross amplification of microsatellite loci in the cacti species from Brazilian chaco. Molecular Biology Reports 2020; 47(2), 1535-1542.
[28] JM Tsholofelo, FM Mathabatha, F Herman and MC Gesine. Genetic diversity and differentiation of South African cactus pear cultivars (Opuntia spp.) based on simple sequence repeat (SSR) markers. Genetic Resources and Crop Evolution 2023; 71(1), 373-384.
[29] KI Ereifej, H Feng, T Rababah, A Almajwal, M Alu’datt, S Gammoh and LI Oweis. Chemical composition, phenolics, anthocyanins concentration and antioxidant activity of tenwild edible plants. Food and Nutrition Sciences 2015; 6(7), 581-590.
[30] I Rabino and AL Mancinelli. Light, temperature, and anthocyanin production. Plant Physiology 1986; 81(3), 922-924.
[31] B Habibeh, A Ghasemnezhad, M Alizadeh and AS Mahonak. Optimizing callus induction and analyzing in vitro phytochemicals in San Pedro cactus (Echinopsis pachanoi). Journal of Horticulture and Postharvest Research 2024; 7(2), 197-212.
[32] MR Martıinez, APBL Rosa, F Gueraud, AN Salvayre, M Rossigno and MDSS Diaz. Establishment of callus and cell suspensions of wild and domesticated Opuntia species: Study on their potential as a source of metabolite production. Plant Cell, Tissue and Organ Culture 2016; 124, 181-189.
[33] TL Ho, S Te-Chato and S Yenchon. Callus induction and plantlet regeneration systems in Indica rice (Oryza sativa L.) Cultivar Sangyod. Walailak Journal of Science and Technology 2018; 15(10), 753-763.
[34] A Libin, PJH King, KH Ong, JK Chubo and P Sipen. Callus induction and plant regeneration of Sarawak rice (Oryza sativa L.) variety Biris. African Journal of Agricultural Research 2012; 7(30), 4260-4265.
[35] K Tongtape, S Te-chato and S Yenchon. Somatic Embryo (SE) formation from culturing floral explants of rubber tree (Hevea brasiliensis Muell. Arg.) and assessment of genetic stability by RAPD and SSR markers. Trends in Sciences 2023; 20(9), 6728.
[36] N Maharik, SE Elgengaihib and H Taha. Anthocyanin production in callus cultures of Crataegus Sinaica Boiss. International Journal of Academic Research 2009; 1, 30-34.
[37] DAL Valler. In-vitro production of anthocyanin in Sesbania grandiflora (Red Katuray) as influenced by varying concentrations of 2,4-D and BA added on MS medium. American Journal of Plant Sciences 2016; 7(15), 2297-2306.
[38] K Matsumoto. Micro-propagation of bananas. In: SM Jain and K Ishii (Eds.). Micropropagation of woody trees and fruits. Kluwer Academic Publishers, Alphen aan den Rijn, Netherlands, 2003, p. 353-380.
[39] A Karthikeyan, SK Pandian and M Ramesh. Agrobacterium-mediated transformation of leaf base derived callus tissues of popular indica rice (Oryza sativa L. sub sp. indica cv. ADT 43). Plant Science 2011; 181(3), 258-268.
[40] R Kawi. Plant tissue culture: Principles and techniques, type II 3. Agronomy Department, Faculty of Agriculture, Kasetsart University, Bangkok, Thailand, 2002.
[41] Y Meksuwan1 and P Sutthinon. In vitro propagation and histochemical analysis of Launaea sarmentosa (Willd.) Kuntze. Trends in Sciences 2023; 20(5), 5729.